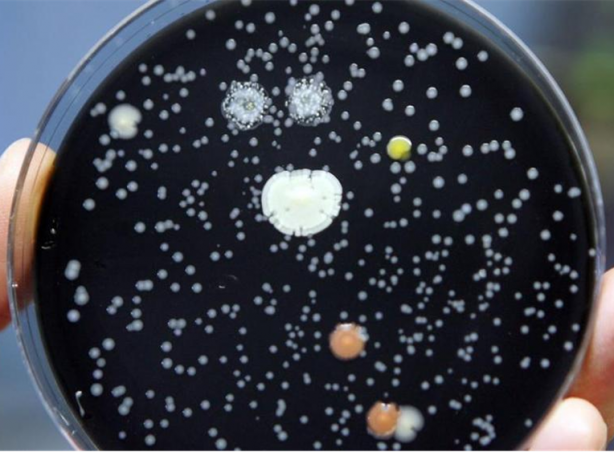
Foto - Lejyonella bakterisi nedir? Bu seferki çok fena, can alıyor! Hastaneden salgın iddiası gündem oldu: İçme suyundan bulaşıyor

Lejyonella bakterisi nedir? Bu seferki çok fena, can alıyor! Hastaneden salgın iddiası gündem oldu: İçme suyundan bulaşıyor
Polonya'nın Rzeszow kentinde şebeke suyu nedeniyle lejyoner hastalığı salgını başladı.Bir akciğer rahatsızlığı olan lejyoner hastalığına yol açan lejyonella bakterisi Polonya'yı etkisi altına aldı. Bu kimyasallar kana karışıyor ve başka dokulara da zarar veriyor Ülkenin güneydoğusunda bu bakteri nedeniyle Polonya'da 3 kişi, bir tür akciğer rahatsızlığı olan lejyoner hastalığına yol açan lejyonella bakterisi nedeniyle hayatını kaybetti. Corona virüs çeşitli varyantlarla dünyada milyonlarca kişinin hayatını kaybetmesine neden olurken Dünyayı diken üstünde tutan yeni salgın alarmı verildi: Lejyoner ölümleri başladı.